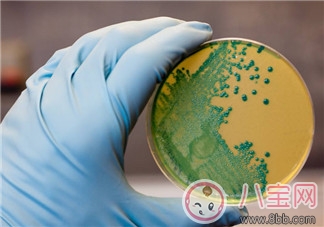
南非為什么引發李斯特菌病疫情  李斯特菌病疫情能治療嗎

時間:2018-01-10 09:12:30來源:本站整理作者:liliang點擊:
人們總是覺得天災不可躲,但是常常人們對于人禍的疾病的抵抗能力也是非常的弱的,尤其是最近的一種疫情讓大家聞風喪膽,南非為什么引發李斯特菌病疫情呢?很多的人都在為他們哀悼,科技的落后遇上了疫情,能活著的患者真的是上天的憐憫了。下面八寶網的小編為大家分享南非李斯特菌病疫情現狀,大家一起來看李斯特菌病疫情能不能治療吧。
南非衛生部表示,他們已經在比勒陀利亞關閉了一家家禽屠宰場,在那里他們發現了引發這種疾病的蟲子。不過,衛生部門目前還不清楚該屠宰場是否就是本輪疫情暴發的源頭。
一位食品微生物學家在接受媒體采訪時警告說,疫情的暴發規模是空前的,應當引起警惕。如果不能緊急有效阻止該病傳播,形勢還將進一步惡化。
李斯特菌中毒是一種細菌感染,可能會通過冷切肉、家禽、未經消毒的牛奶,以及新鮮水果和蔬菜等傳播。李斯特菌可引起流感癥狀和腹瀉,更嚴重的情況是從腸道擴散到血液,引起敗血癥,或造成中樞神經系統感染,誘發腦膜炎。新生兒、老人、孕婦和因感染艾滋病而導致免疫力下降的人都是易感染人群。

中新社約翰內斯堡1月8日,南非衛生部長莫措阿萊迪在一個新聞發布會上透露,在該國暴發的李斯特菌病(李氏桿菌病)已造成61人喪生。
這是莫措阿萊迪連續第二個月公布該病的疫情進展。去年12月5日,他公布的死亡人數是36人,感染病例557個。統計顯示,這波疫情從去年1月份開始暴發,目前已經確認至少有720人感染病毒,且成加劇狀態。
南非行政首都比勒陀利亞和最大城市約翰內斯堡所在的豪登省是報告病例最多的省份,在已報告的727個病例中,有442個發生在該省。此外,西開普省也報告了92個病例。

雖然死亡率高達20%到30%,但這種病并非無藥可救,可以通過抗生素藥物來醫治。
南非衛生部門的官員說,李斯特菌并沒有耐藥性,引發死亡的主要原因是診斷延誤,造成感染者沒有得到及時治療。莫措阿萊迪敦促任何有李斯特菌感染癥狀的人盡快就醫:“如果你有上述癥狀請盡快去求醫問藥。不要若無其事地坐在家里,尤其是你在夏天還有感冒癥狀。”
多數抗菌藥對李斯特菌具有抗菌作用,其中氨芐西林與青霉素療效最佳。紅霉素、利福平、復方SMZ-TMP、氟喹諾酮類、克林霉素、萬古霉素、氯霉四環素、頭孢噻吩等也有效,尚無耐藥菌出現。治療延誤及嚴重新生兒敗血癥或腦炎病人常導致治療失敗。青霉素或氨芐西林聯合氨基糖苷類對本菌常呈協同作用,敗血癥病人宜用藥2周以上,腦膜腦炎療程3周以上,心內膜炎4~6周,腦膿腫的療程應超過6周。

1.一般進行抗菌治療,氨芐西林為最佳首選藥物,對孕婦及嬰兒安全,且能在腦內達到有效濃度。(1)腦膜炎患者氨芐西林靜脈給藥,療程3~4周。(2)免疫功能障礙者用氨芐西林聯合慶大霉素治療。
2.青霉素(1)心瓣膜受染患者用青霉素聯合妥布霉素治療。(2)對青霉素過敏者采用甲氧芐啶聯合磺胺甲咪唑,靜脈給藥。
3.其他抗生素四環素、氯霉素、紅霉素、卡那霉素、磺胺嘧啶等也有效。

網友跟帖
Copyright 2015-2020 8bb.com 〖八寶網〗 版權所有 鄂ICP備19016373號-1
聲明: 本站文章均來自互聯網,不代表本站觀點 如有異議 請與本站聯系 本站為非贏利性網站 不接受任何贊助和廣告
網友評論僅供其表達個人看法,并不表明八寶網立場。